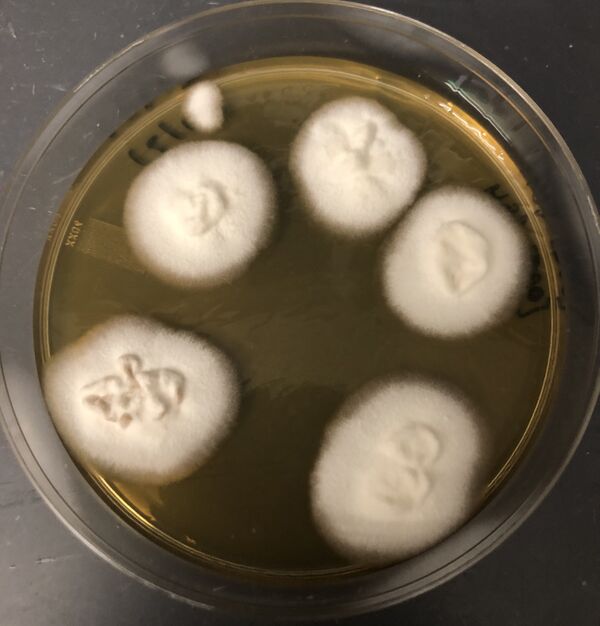

Liquid-based Agrobacterium-mediated transformation
From OpenWetWare
Jump to navigationJump to search
Protocol content forthcoming.
-
Cartoon of A. tumefaciens-mediated transformation of fungi, R. Perez 2020.
-
Representative image of first selection of liquid-based Agro.-mediated transformation. Blue box indicates samples without A. tumefaciens and without hygromycin B. Red box indicates samples without T-DNA and with hygromycin B.